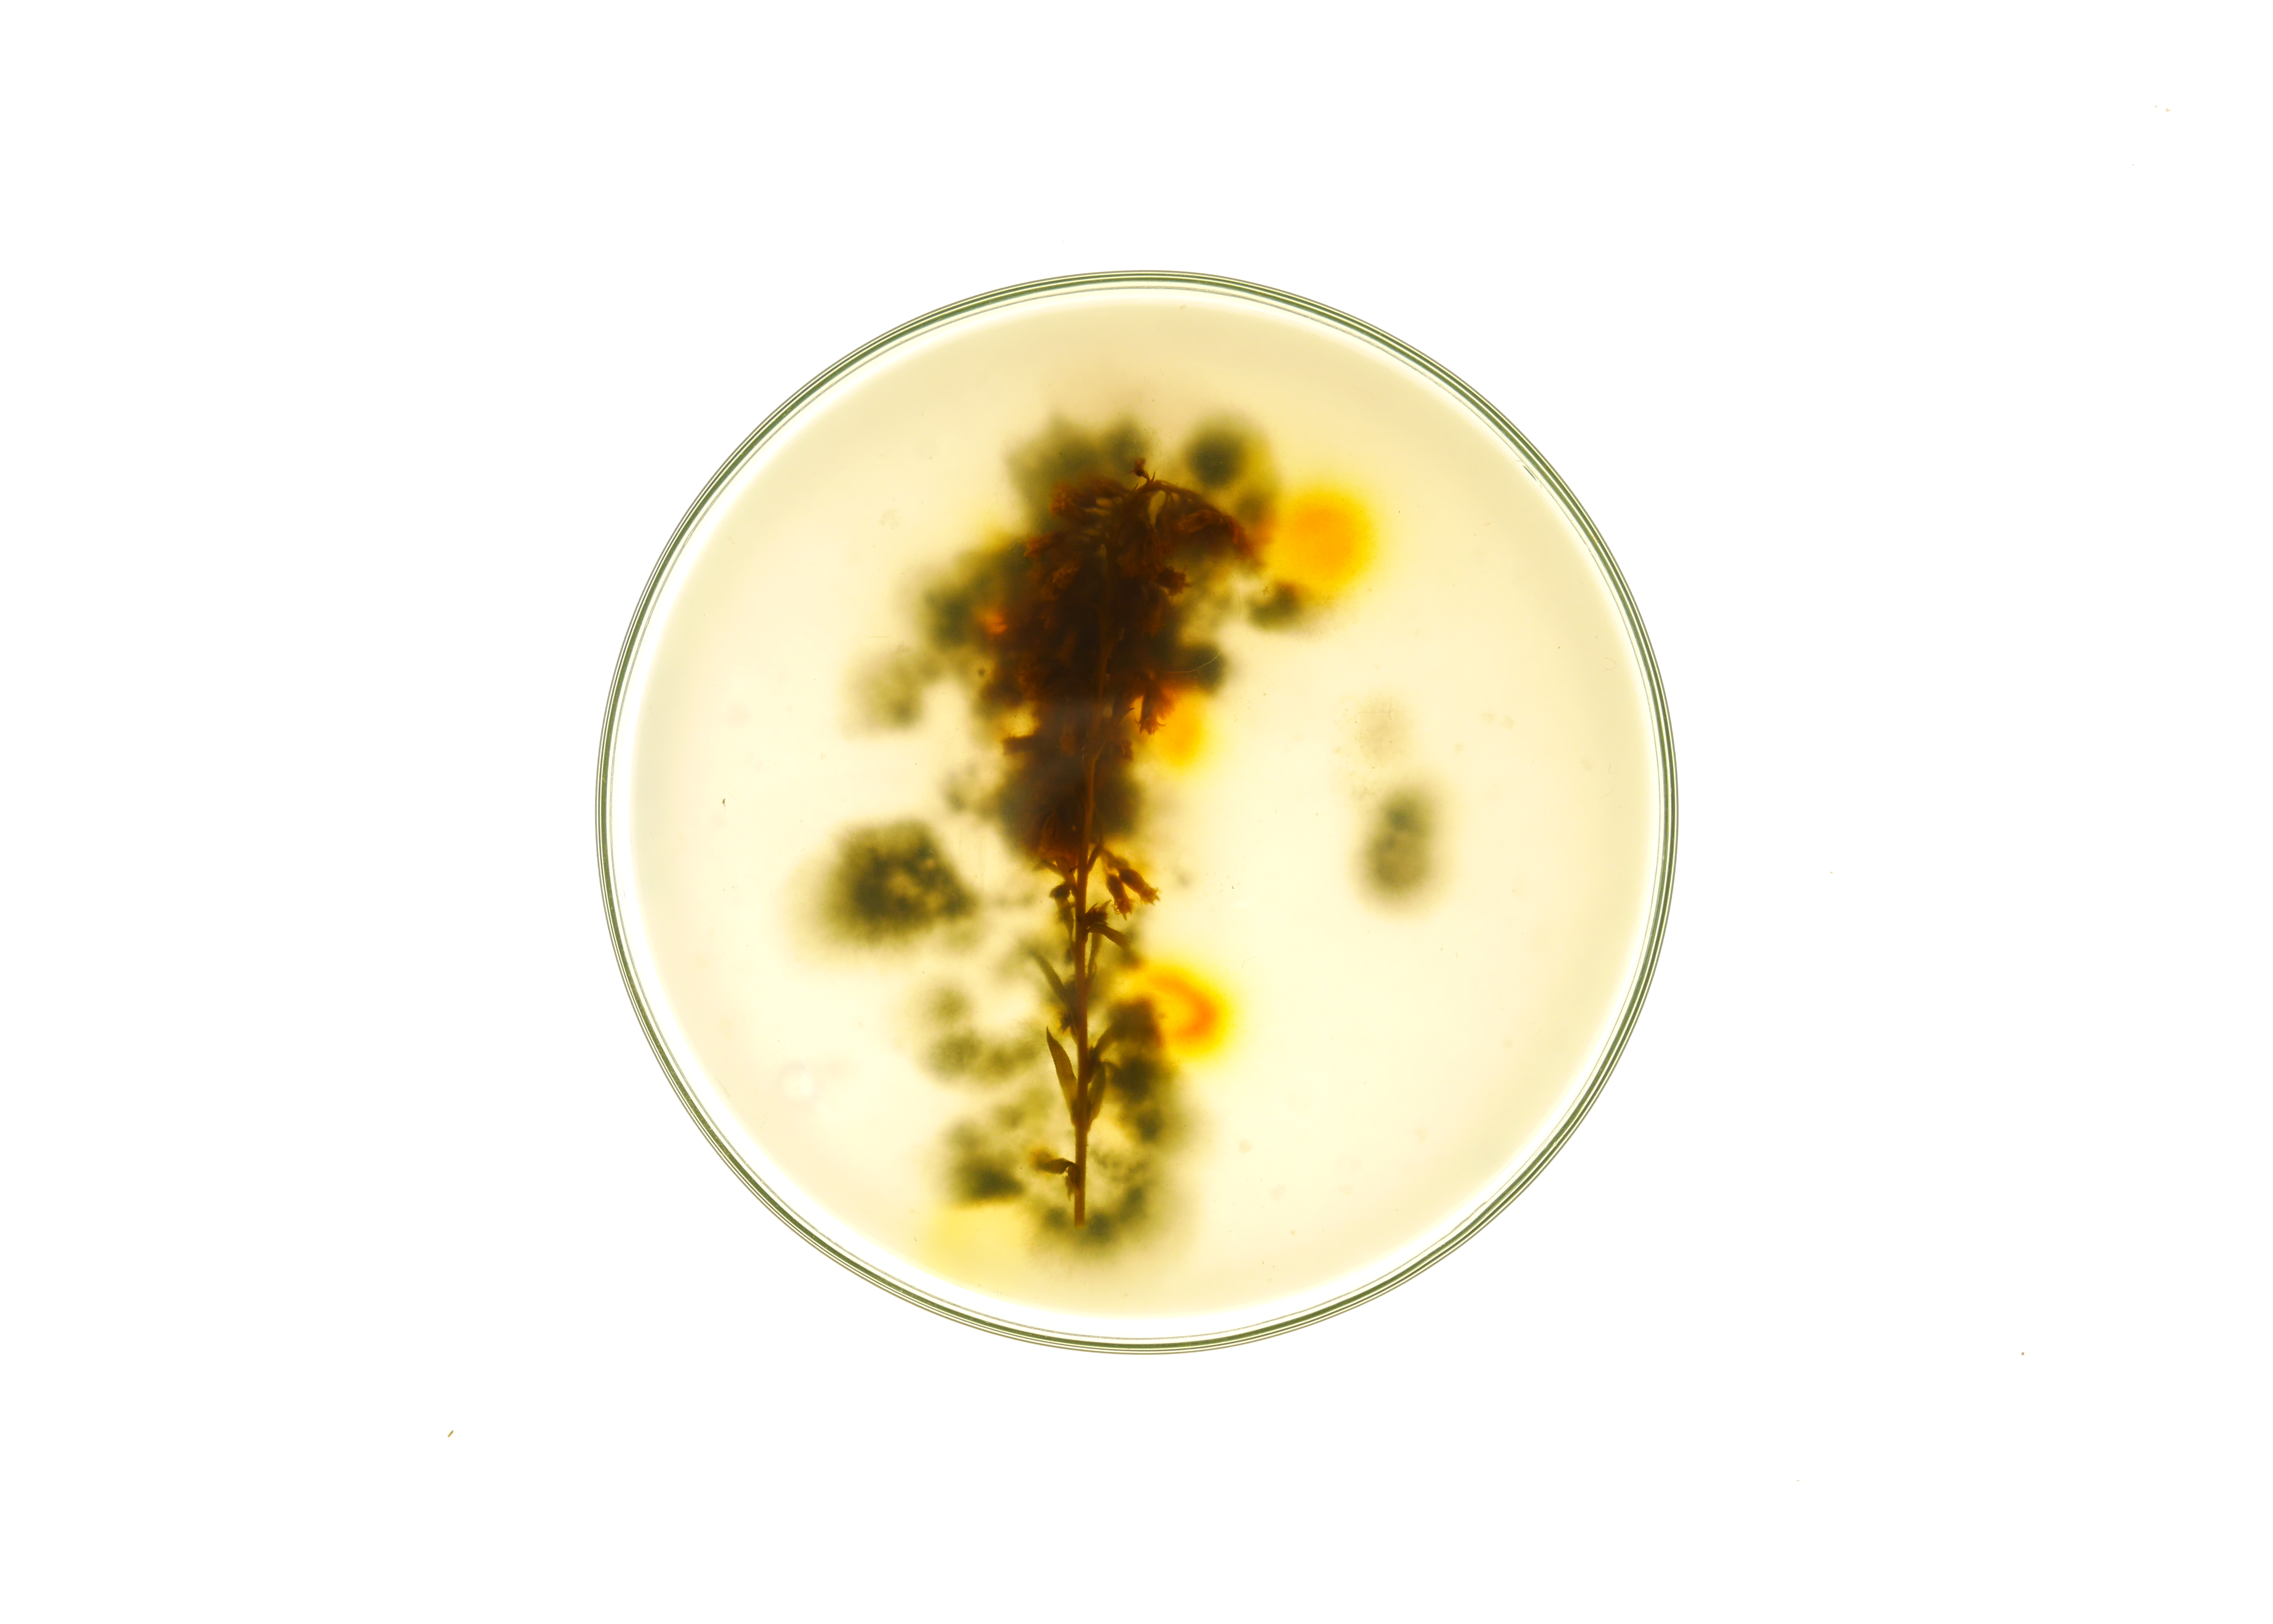
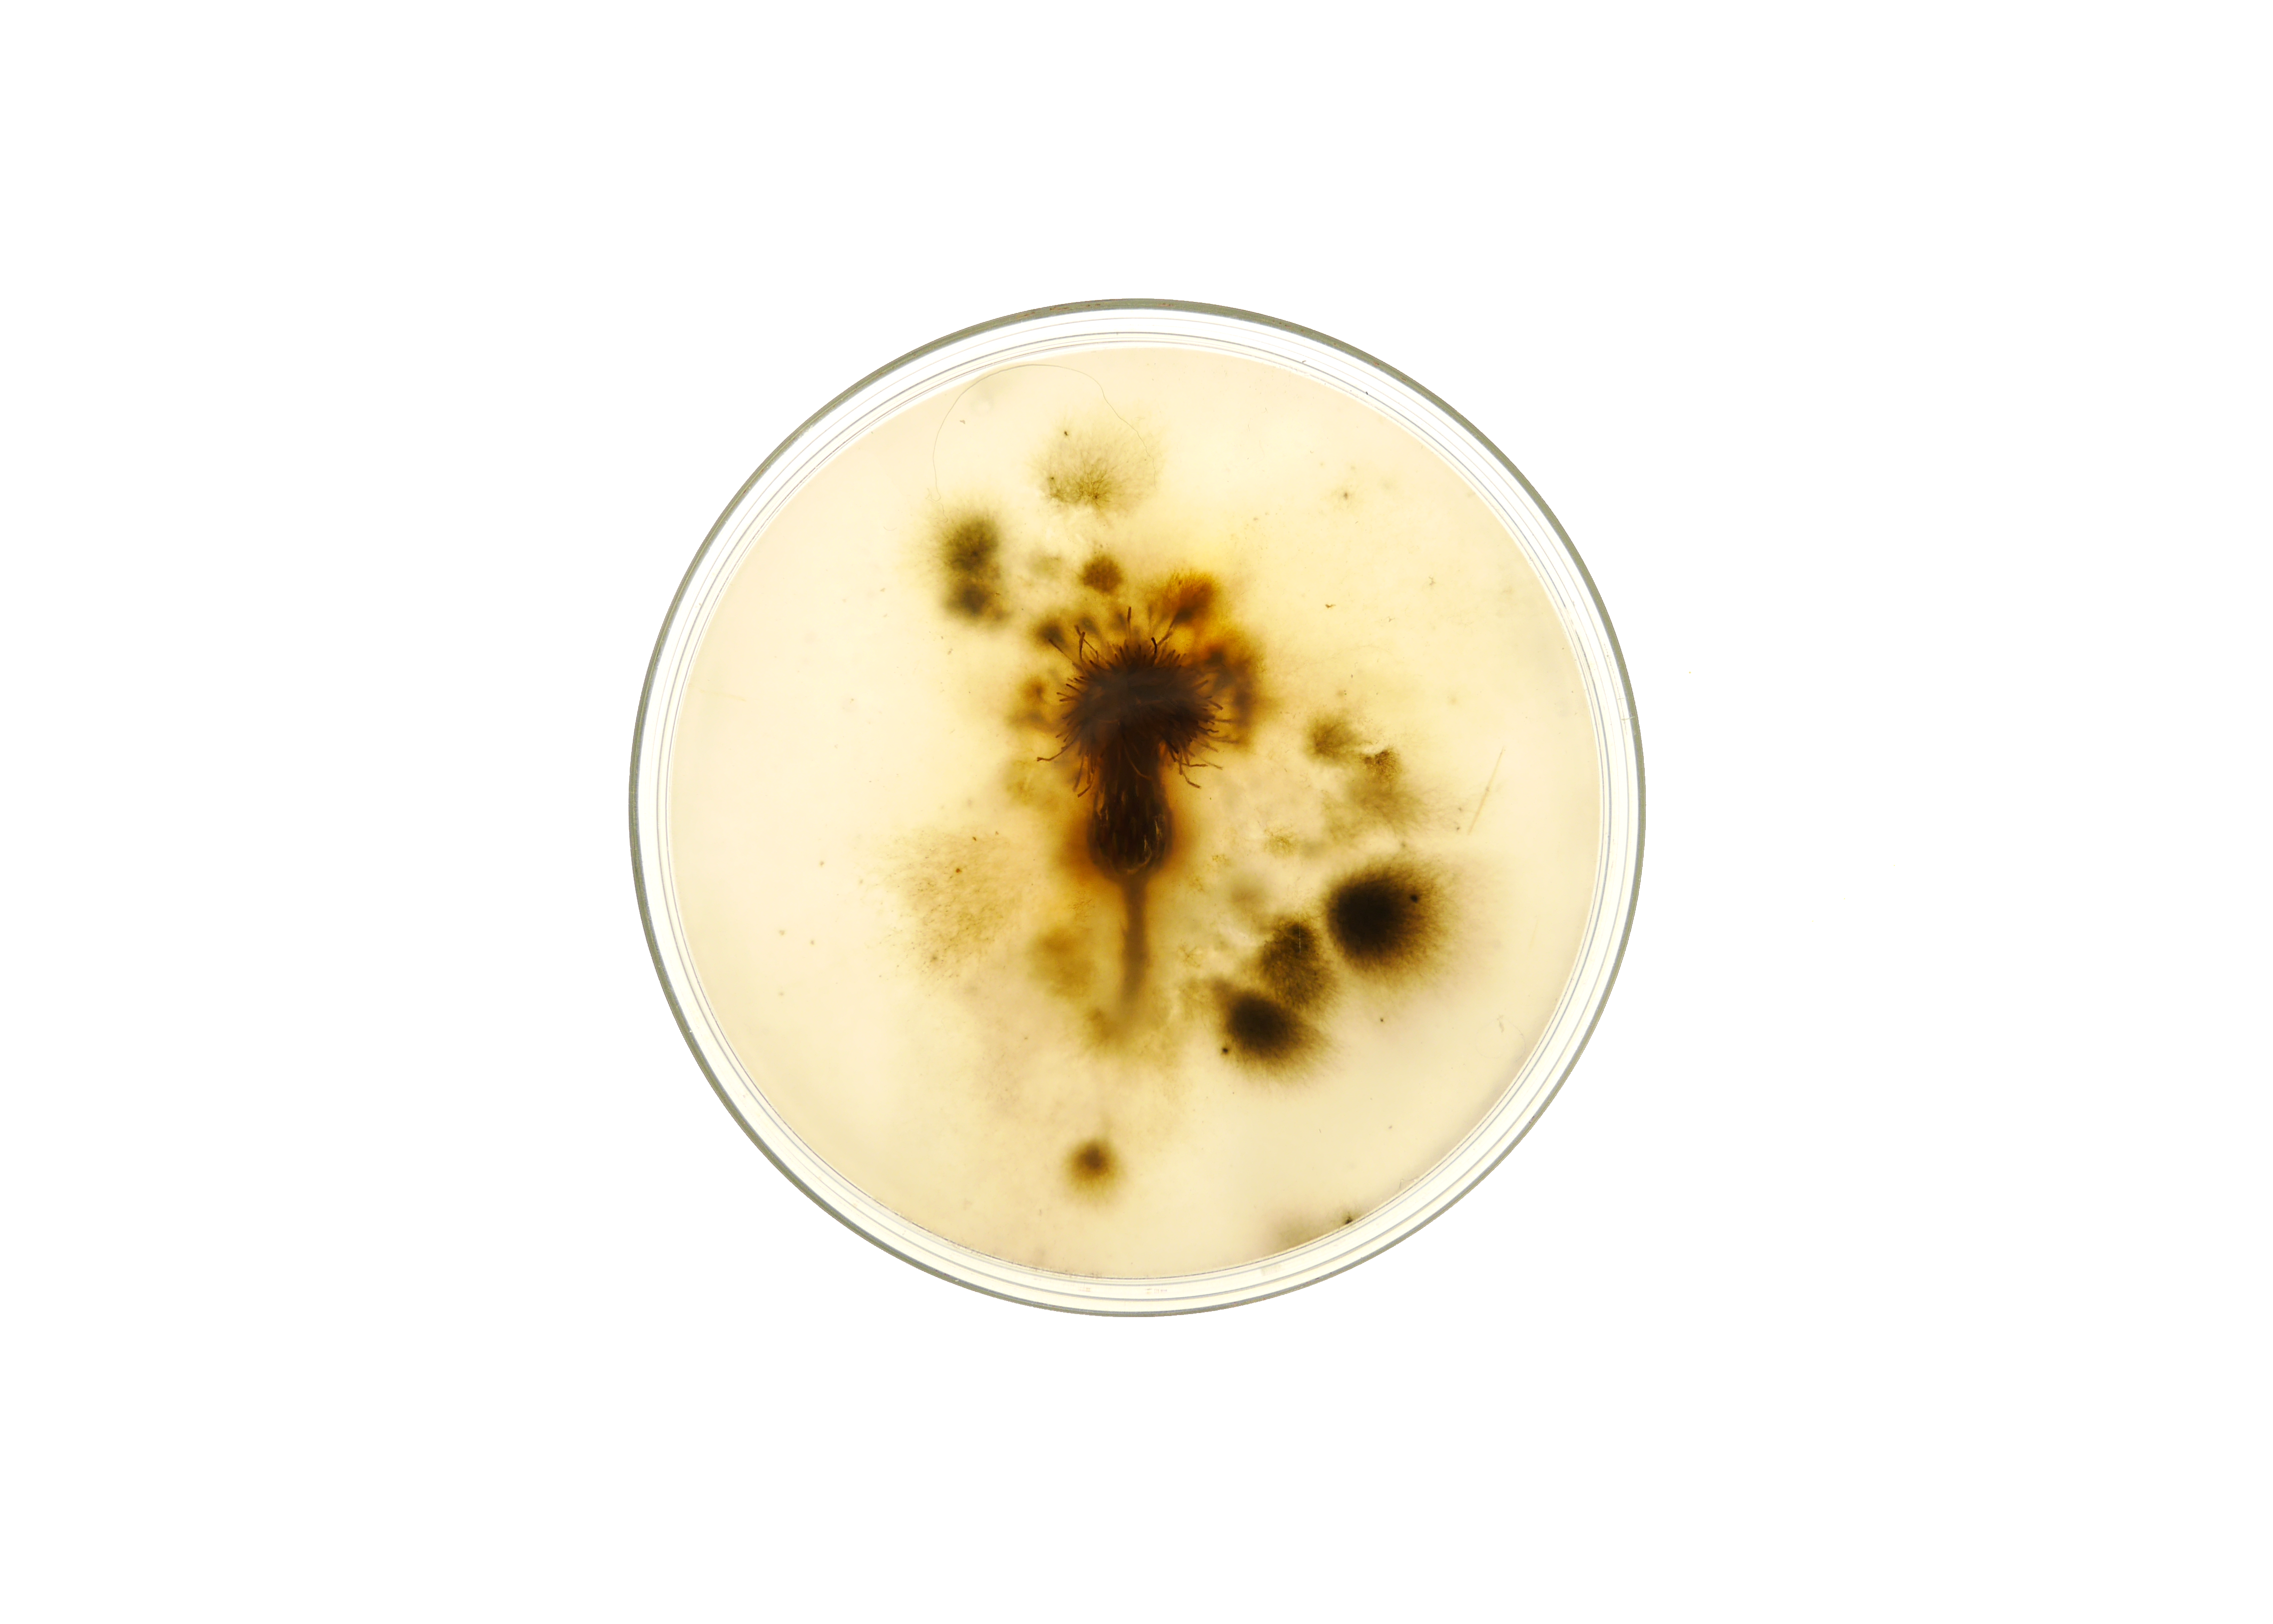
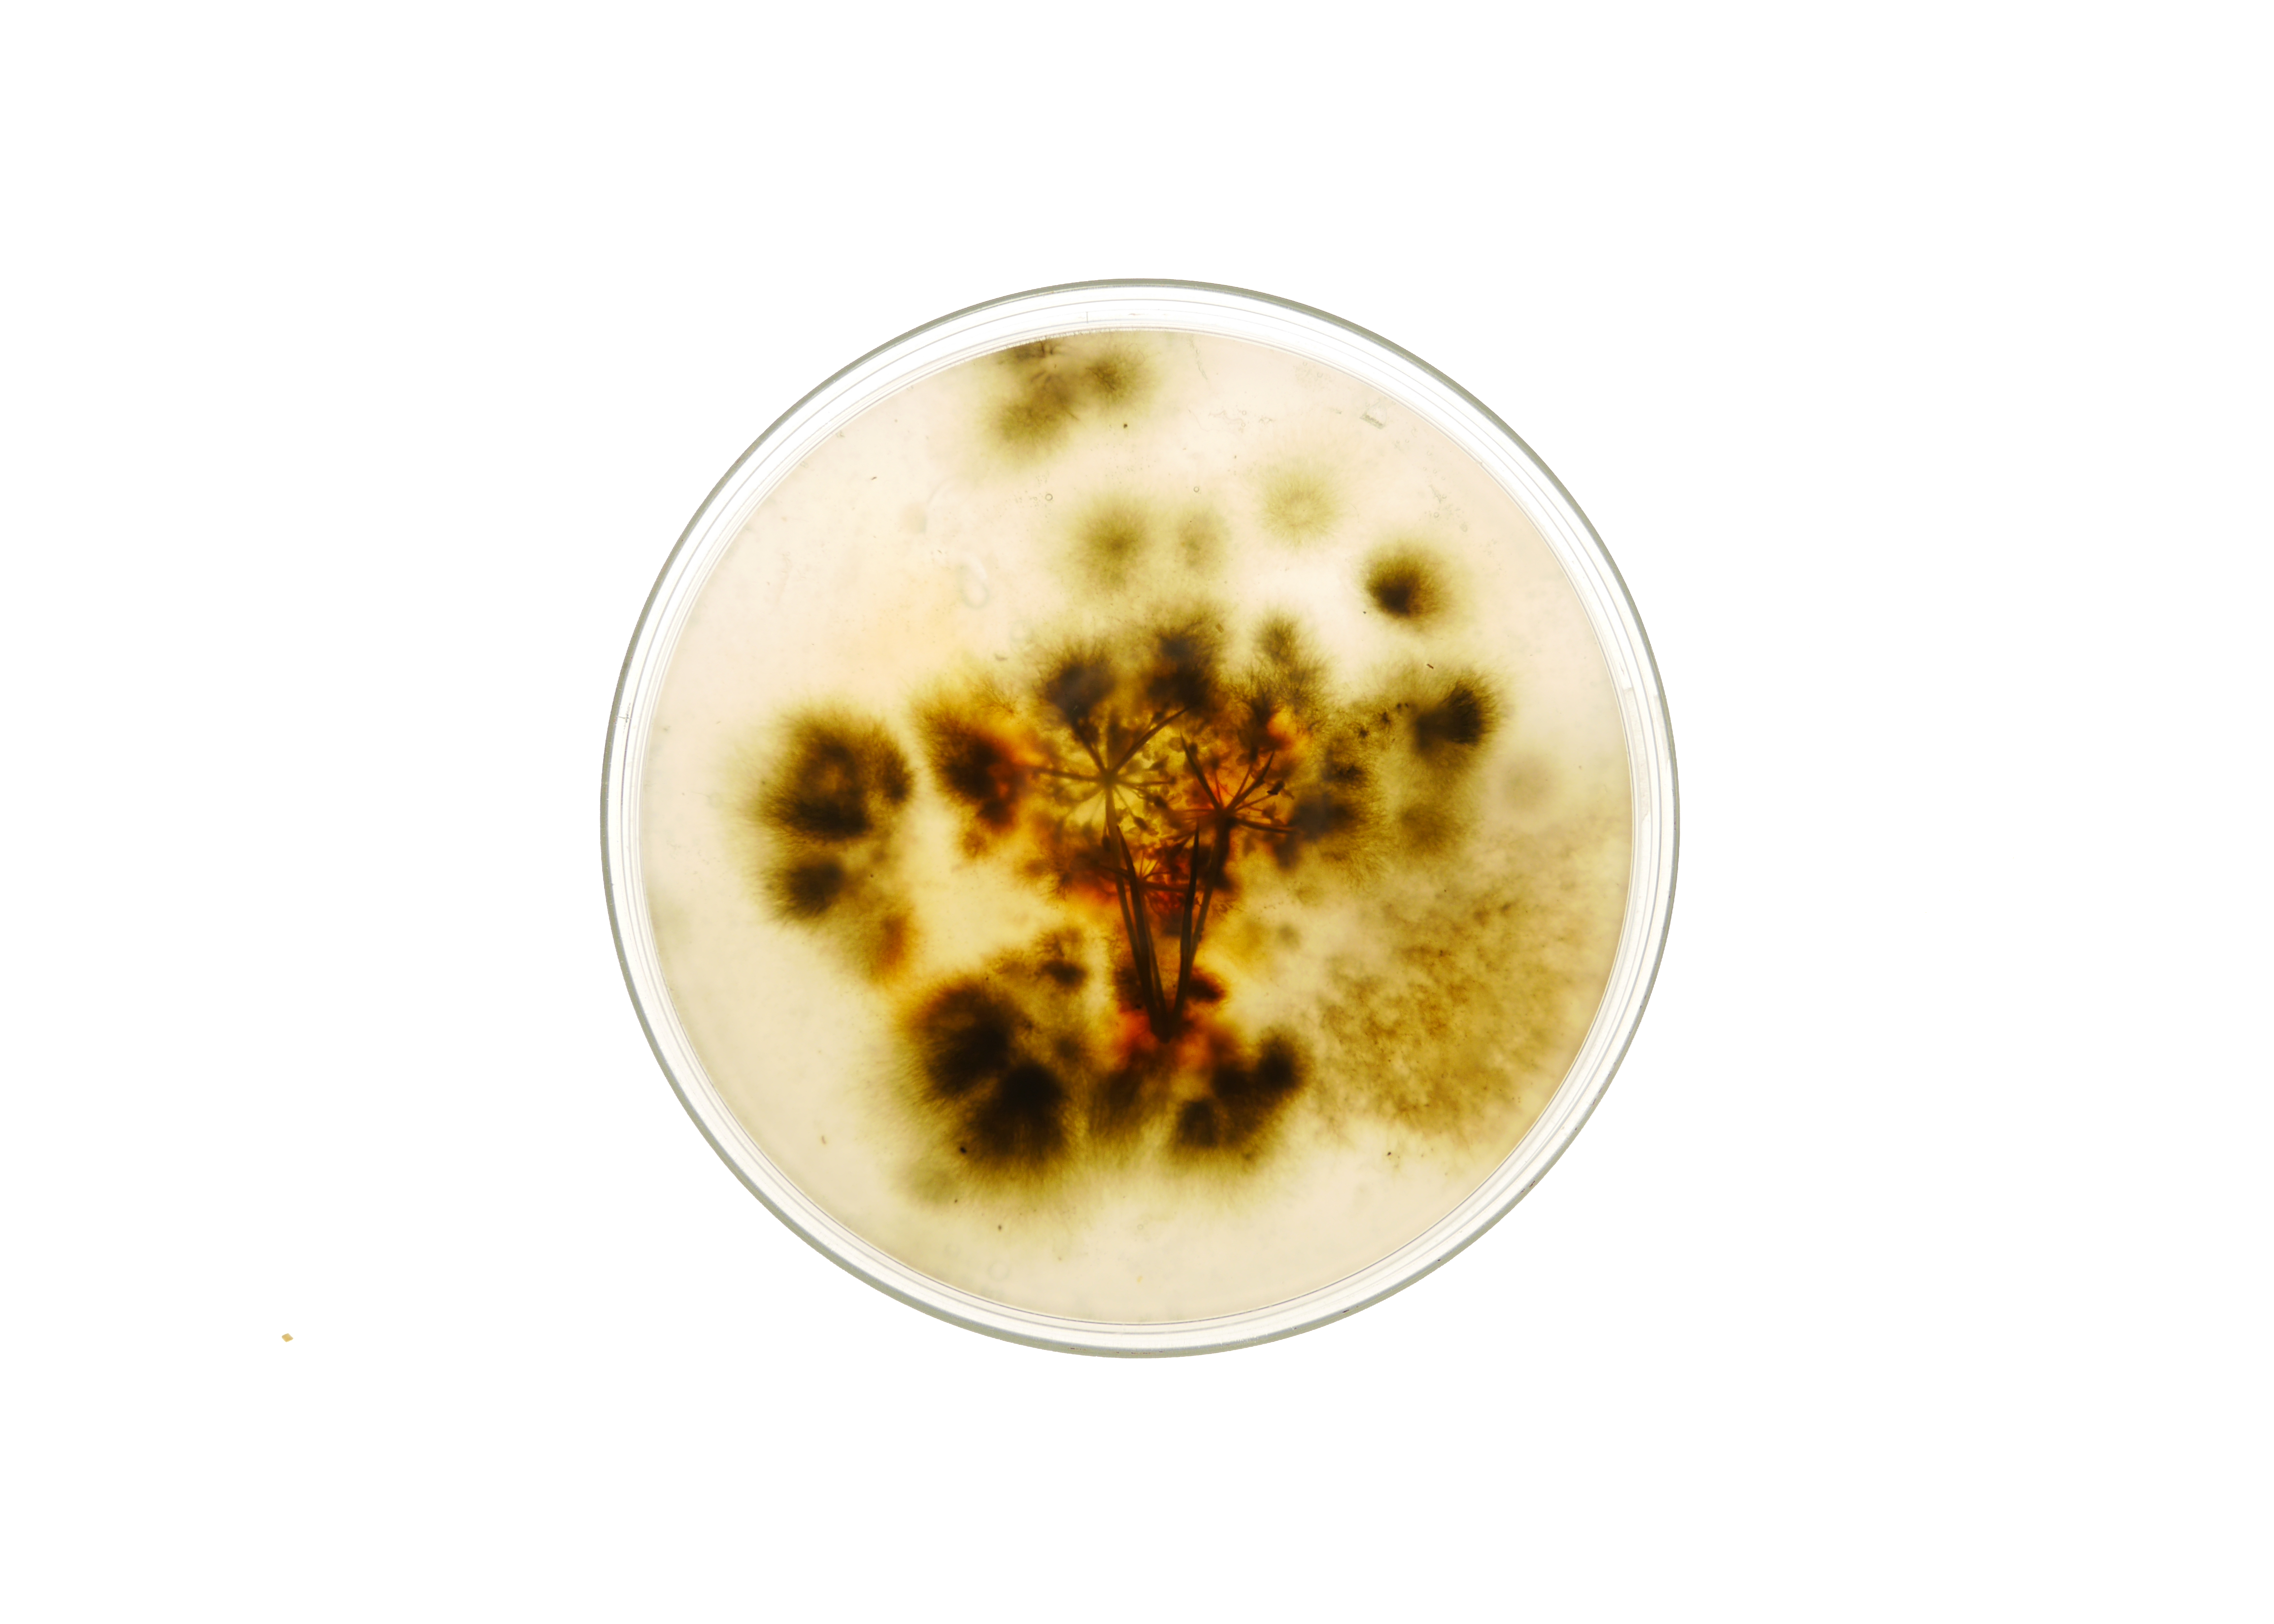
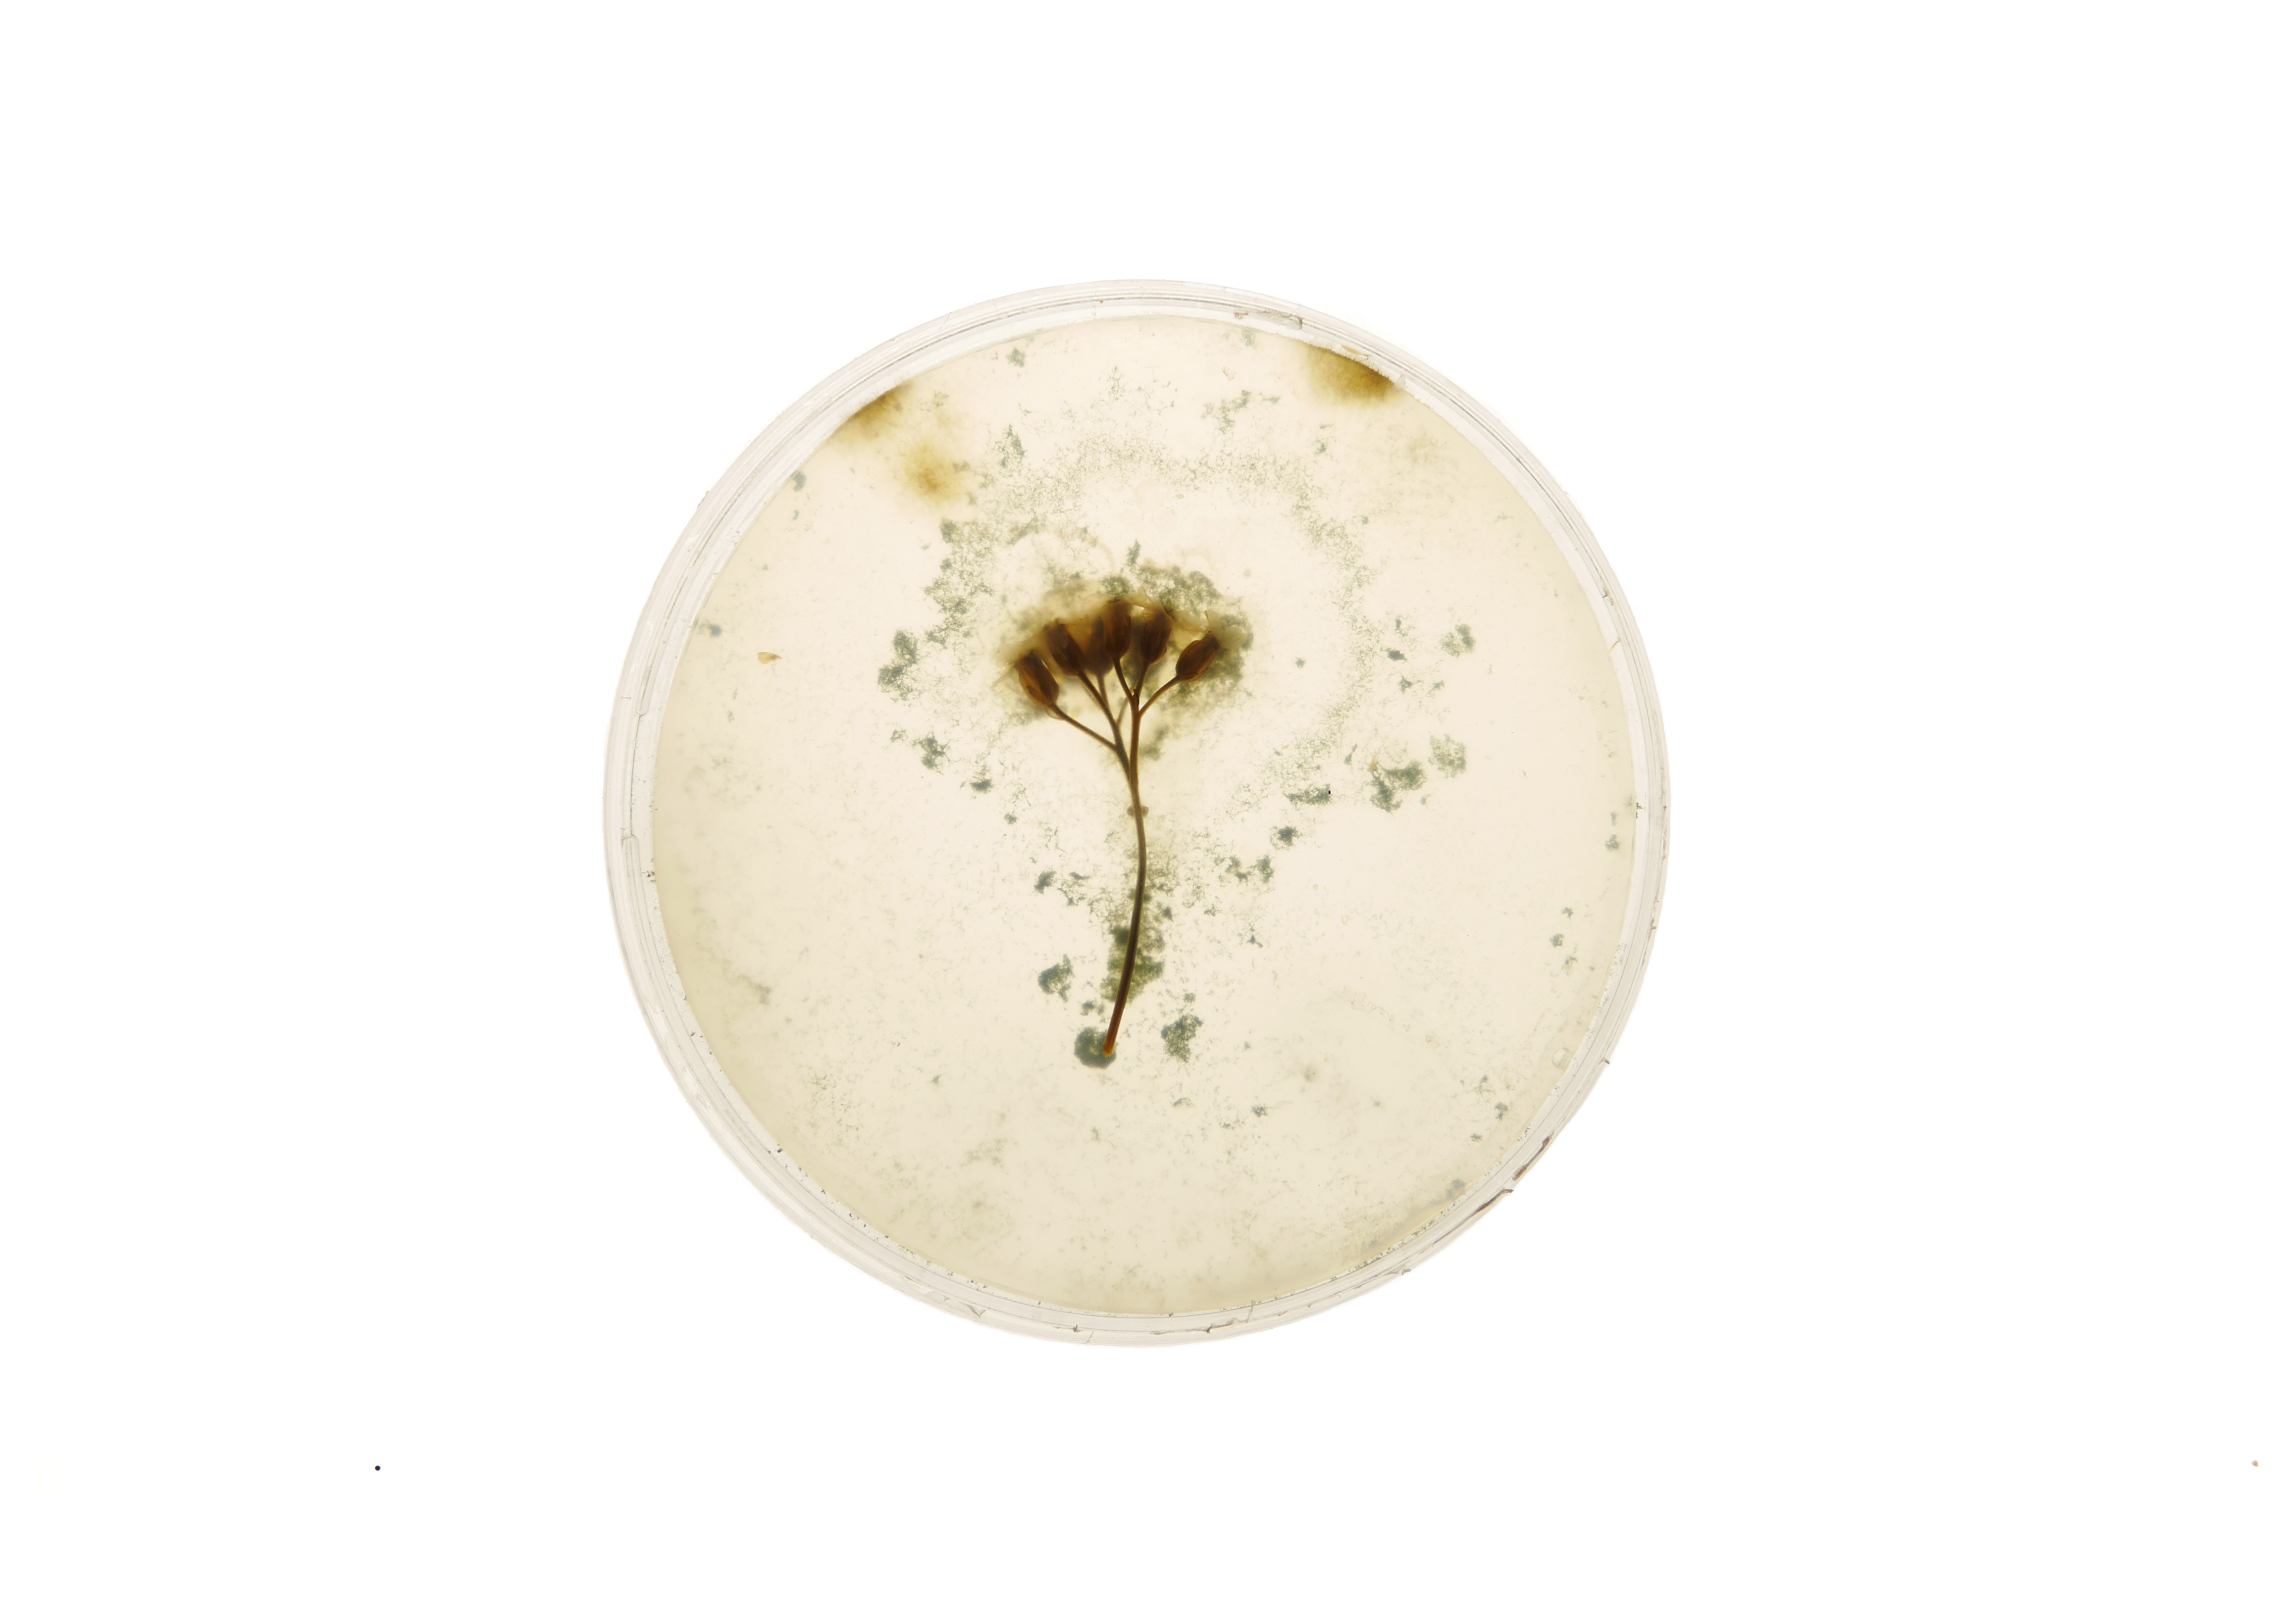

Broderies, 2022
Exposition Cultures Sauvages, Frac Picardie, Amiens, 2022.
Agar-agar, feuilles d’achillée millefeuille, géranium à robert, micro-organismes, composées phénoliques, métal, lumières.
60×60 cm
Traditionnellement, on brode des fleurs et des feuilles. A la manière d’un tissu que l’on tend sur un tambour à broder, l’étoffe d’agar-agar est elle aussi tendue et laisse apparaitre ses motifs végétaux, bien réels ici, des plantes entourées de leurs micro-organismes.




Les entrailles de la matière, 2021.
Exposition Cultures Sauvages, Frac Picardie, Amiens, 2022.
Installation, agar-agar, plantes sauvages, jus de chélidoine et de tanaisie, composés phénoliques, tables lumineuses.
Une autre vision de la plante est montrée, de ses propriétés aux jus qu’elles dégagent.
Les matières sont coupées, cousues, épinglées, des peaux disséquées rendues visibles par des tables lumineuses.
De l’imaginaire de la dissection ; une plongée microscopique à la lisière du visible.

Les espèces compagnes #1, 2021.
Exposition Cultures Sauvages, Frac Picardie, Amiens, 2022.
Série photographique de 20 impressions sur papier.
50x70cm
Les espèces compagnes, expression empruntée à la philosophe des sciences Donna Haraway, comprend à la fois une série d’impressions photographiques et une série de boîtes de pétri activées au début de l’exposition.
Pour cette série photographique, pendant plusieurs mois, j’ai constituée une sorte d’herbier de plantes et de fleurs sauvages que j’ai plongé dans l’agar-agar couplé à un milieu nutritif, dans des boites de pétri, que j’ai ensuite photographié.
En se réappropriant des techniques propres au laboratoire de biologie végétale, je montre ce qui est invisible à l’œil nu : les micro-organismes qui cohabitent avec les plantes.
En rendant visible les micro-organismes présents sur les plantes, je tente de montrer les relations qui nous unissent entre les différentes espèces et à différentes échelles, pour tenter de reconfigurer nos imaginaires où le commun et la symbiose serait valorisé, pour se réapproprier nos relations au vivant.




Les espèces compagnes #2, 2022
Exposition Cultures Sauvages, Frac Picardie, Amiens, 2022.
Boites de pétri en verre, agar-agar, plantes sauvages
Les espèces compagnes, expression empruntée à la philosophe des sciences Donna Haraway, comprend à la fois une série d’impressions photographiques et une série de boîtes de pétris activées au début de l’exposition.
Peu avant le début de l’exposition, je suis venue récolter des plantes spontanées autour du FRAC Picardie, qu’elle a plongé dans un milieu de culture nutritif d’agar-agar.
Au fur-et-à-mesure de l’exposition, les micro-organismes qui cohabitent avec les plantes vont se développer dans la matière et deviendront visible à l’œil nu. Ainsi, le public pourra contempler un instant de l’évolution des micro-organismes présents sur les plantes lorsqu’ielles visiteront l’exposition.




Les invisibles, 2020
Série de 5 moulages de 40x25cm
Fécule de pomme de terre, inclusion d’Eupatoire à feuilles de
Chanvre, de Vergerette du Canada, de Sénéçon du Cap




Laisser infuser, 2020
43X39 cm
Agar-agar, Pétales de fleurs d’Arbre à Papillon (Buddleia de Davis), fleurs de Tanaisie, fleurs et boutons de fleurs de Séneçon du cap, pétales d’Eupatoire à feuilles de Chanvre




Actinia Schmidtti, 2020
Dimensions variables
Agar-agar, jus de betterave, jus de spiruline, fleurs de Tanaisie




Membranes, 2020
Série de 4 «membranes» de 120X75cm
Fécule de pomme de terre, feuilles de cymbalaire, feuilles de géranium à robert, feuilles de capillaires des murailles
Partir d’une observation à partir de processus scientifiques réappropriés,
La dévoiler,
La déployer pour ouvrir nos imaginaires.
Le projet « Cultures sauvages » part d’une expérience, celle d’une résidence de plusieurs jours dans des laboratoires scientifiques. Une immersion où des liens se créent, où les pratiques s’entrecroisent, où les processus se mêlent et les démarches s’entrechoquent.
Cette résidence s’est déroulée à l’Université de Lille avec l’aide de deux scientifiques : Ségolène Arnauld, ingénieure Plateforme technologique agro-alimentaire de Polytech Lille, et Caroline Rambaud, chercheuse et maitresse de conférence à l’Institut Charles Viollette, dans le cadre de la Biennale Watch this Space #11 organisée par 50° Nord.
Marie Van de Walle est partie d’un commun qui la liait au laboratoire et à sa pratique artistique, et plus exactement celle d’une matière : l’agar-agar. L’agar-agar est utilisé dans les laboratoires comme ingrédient de base des milieux de culture des plantes et des micro-organismes. C’est un support qui permet la culture in vitro de plantes mais aussi de cellules, de bactéries, de levures, de moisissures afin de permettre leur étude.
L’agar est également une matière que l’artiste utilise dans ses recherches de créations de nouveaux matériaux. C’est une matière qui l’intéresse par son aspect évolutif et qu’elle déploie formellement ; parfois comme matière souple qu’elle utilise comme un tissu, parfois comme support de développement
de micro-organismes ou comme matière liquide qu’elle coule sur différents supports.
Ici, tout se dégrade, les oeuvres sont évolutives, la matière craquèle, se rétracte, les formes et les couleurs changent en interaction avec notre environnement : le temps, la température de la pièce, la lumière du soleil, l’air, les
micro-organismes qui interagissent dans notre écosystème commun…
Marie Van de Walle propose une fiction utopique où la matière raconte une histoire, un monde fait d’interdépendances et de connexions entre le visible et l’invisible.
